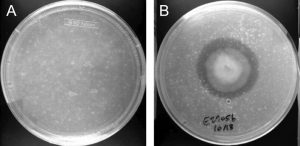
zam999102437000_20211119-195959_1.jpeg

Conheça o fungo amazônico que come plástico
A descoberta foi realizada em 2011 por um grupo de estudantes da Universidade de Yale que visitavam a Amazônia Equatoriana Um grupo de estudantes norte-americanos da Universidade de Yale realizou uma descoberta em 2011 ao visitarem a Amazônia Equatoriana: uma espécie de fungo que se alimenta de plástico. O Pestalotiopsis microspora tem a sua dieta composta exclusivamente por … Continue lendo Conheça o fungo amazônico que come plástico